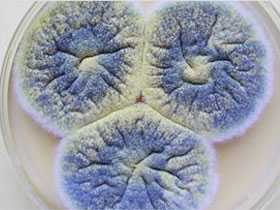

Как уничтожить плесень | Делимся советами
Плесень может появиться в любом доме и стать возбудителем разных заболеваний, аллергии, например. Поэтому обнаружение и удаление плесени очень важно для того, чтобы сделать дом безопасным и пригодным для проживания.
Вред плесени
Плесневые грибки подавляют иммунную систему, вызывают разные аллергические реакции — кашель, насморк, ощущение нехватки воздуха. Иногда сложные, трудно диагностируемые, хронические болезни, успешно излечиваются, когда человек меняет жилье и поселяется в сухой квартире без плесени.
Кроме того, серые или черные пятна, грязный налет портит внешний вид вещей.
Причины появления плесени
Чтобы раз и навсегда избавиться от плесени в доме, прежде всего необходимо определить причины ее появления. Микроскопические споры присутствуют всюду, в воздухе, воде, и едва лишь они попадают в благоприятную среду, сразу же начинают разрастаться. Наиболее частыми причинами появления плесени являются высокая влажность и недостаток вентиляции. Плесень является простейшим грибком, а он, в свою очередь, любит влажность и помещения с плохой вентиляцией. Сырые дома, квартиры на первом этаже, неразумное использование увлажнителей, разведение большого количества тропических комнатных растений в маленькой комнате – все это может стать причиной появления плесени.
Среди современных строительных и отделочных материалов практически не найти таких, которые не подвержены влиянию плесени. Она часто появляется в ванных комнатах, туалетах, на фильтрах кондиционеров. Может также быть обнаружена в стиральной машине или в холодильнике, на книгах, обоях и просто на стенах. Избавиться от плесени бывает очень трудно.
Первым признаком плесени является специфический запах, сырой и острый. Потом можно заметить пятна серого, черного или беловатого цвета.
Если в дом появилась плесень, то прежде чем начать избавляться от нее, обязательно сначала решить проблему повышенной влажности и плохого проветривания, иначе она будет появляться снова и снова.
Проблема избавления от плесени решается в комплексе. Недостаточно просто отмыть и отскрести наросты грибка, нужно обязательно создать такой микроклимат в доме, при котором новая плесень не появится никогда.Вот основные направления работы по уничтожению плесени в доме:
- Очистить механически стены, пол, потолок от плесени
- Обработать все поверхности средством, уничтожающим плесневый грибок
- Выбросить все вещи, глубоко поврежденные плесенью и ставшие непригодными
- Устроить постоянную хорошую вентиляцию в помещении, чтобы воздух не застаивался
- Снизить влажность в помещении. Обнаружить и устранить все источники повышенной влажности.
Средства для удаления плесени
Если проблема уже возникла, вывести плесень их можно с помощью специальных антисептических средств, которые в больших количествах присутствуют на полках магазинов стройматериалов. Важно помнить, что любое химическое средство для удаления плесени, каким бы оно ни было, это яд. Поэтому работать с такими средствами нужно очень осторожно. Перед началом желательно внимательно выучить инструкцию по использованию.
Важно также понимать, что пористые материалы, обои, мягкая мебель иногда настолько поражаются плесенью в глубину, что очистить их практически невозможно и приходится выбрасывать.
Антисептическая грунтовка
Наилучшее проверенное средство для избавления от плесени – это специальная антисептическая грунтовка, которую можно легко найти в магазинах стройматериалов. Такая грунтовка выполняет две функции: помогает избавиться от плесени и защищает от ее появления в дальнейшем.
Антисептическую грунтовку очень просто использовать, обычно она не нуждается в добавлении воды. Если грунтовка неразбавленная, придерживайтесь инструкции, чтобы получить нужный состав для борьбы с плесенью.
Прежде чем начать наносить грунтовку, поверхность нужно очистить. Если грибок проник глубоко в оштукатуренную стену, очень важно очистить все до чистого слоя, может быть даже дойти до бетонной плиты или кирпича. Наносить грунтовку нужно на сухую поверхность и равномерно обычной малярной кистью. Когда грунтовка высохнет, можно наносить краску или клеить обои.
Отбеливатель уничтожает плесень
Домашние средства тоже могут помочь в борьбе с плесенью. Они не настолько эффективны, как специальная грунтовка, но, в то же время менее токсичны.
С помощью обычного отбеливателя можно избавиться практически от всех видов плесени в доме. Активным веществом в нем является гипохлорит натрия. Он убивает и плесень, и ее споры. Отбеливателем можно очищать плитку в ванной, стекла, пол, но многие вещи обесцвечиваются и портятся под воздействием отбеливателя.
Кроме того, отбеливатель выделяет резкие и токсичные пары и разъедает кожу рук. Прежде чем приступить к удалению плесени отбеливателем, обязательно следует убедиться, что помещение хорошо проветривается. Также нужно надеть резиновые перчатки для защиты рук. Поверхность обрабатывают смесью из 1 части отбеливателя с 10 частями воды.
Уксус против плесени
Обычный столовый уксус является слабой кислотой и способен уничтожать многие распространенные разновидности плесени. Он имеет запах, но не выделяет таких опасных испарений, как отбеливатель. Чтобы избавиться от плесени уксус наносят на заплесневелые поверхности с помощью распылителя или протирают смоченной тряпкой. Обычно через час промывают водой и проветривают помещение. Для профилактики появления плесени уксус распыляют каждую неделю на проблемную область.
Перекись водорода убивает плесень
Перекись водорода тоже подходит для борьбы с плесенью, так как это антибактериальное, а также противогрибковое средство. 3% раствор перекиси можно купить в любой аптеке, она не токсична и не выделяет едкого запаха. Перекись водорода эффективно удаляет плесень на многих материалах, но тоже обладает отбеливающим эффектом, поэтому применять следует с осторожностью на тканях и окрашенных поверхностях.
Нашатырный спирт
Нашатырный спирт тоже применяют для уничтожения плесени. Как и отбеливатель, он легко уничтожает грибок на твердых непористых поверхностях, таких как кафельная плитка или стекло, но он не эффективный для удаления плесени из пористых материалов.
Чтобы избавиться плесени при помощи нашатырного спирта, его смешивают пополам с водой и распыляют полученную смесь на зараженную область. Оставляют на несколько часов, потом промывают.
Едкий запах нашатырного спирта может вызвать головную боль и першение в горле. Опасно смешивать отбеливатель с нашатырным спиртом, так как при этом выделяется токсичный газ.
Пищевая сода борется с грибками
Пищевая сода тоже помогает избавиться от плесени. Она поражает грибки и известна как натуральный и безопасный бытовой очиститель. В отличие от других средств, которые содержат агрессивные химикаты, сода не повредит семье или домашним животным. Чайную ложку соды растворяют в стакане воды и опрыскивают пораженную плесенью поверхность. Можно просто промывать губкой в растворе соды поверхности и вещи. Соду с поверхности лучше не смывать полностью, она эффективно защищает он повторного появления опасных загрязнений.
Избавившись от налета плесени с помощью разнообразных средств, вы решите только половину проблем. Вторая половина – обеспечить сухость и регулярное проветривание помещения, где была обнаружена плесень, чтобы не допустить ее повторного появления.
tigress…s
sovet.boltai.com
Как уничтожить грибок черную плесень на стенах обоях и мебели
Причиной появления грибка в доме является повышенная застойная влажность. Стоит только нарушить вентиляцию при ремонте квартиры, и на стенах появляются небольшие пятна, которые затем сливаются вместе. Плесень проникает глубоко в слой штукатурки и разрушает ее. Споры разносятся по воздуху и являются причиной различных заболеваний, особенно у детей. Если вам досталась сырая пораженная грибком квартира, не отчаивайтесь. Любую проблему можно решить. Главное — знать как.

Чтоб уничтожить грибок на стенах Вам понадобится:
- шпатель или жесткая щетка;
- валик;
- тепловентилятор;
- штукатурка;
- шпатлевка;
- состав для удаления следов цемента и штукатурки;
- антисептический раствор;
- акрилатный антисептический грунт;
- гидроизоляционный раствор;
- теплоизоляционная краска.
Порядок провидения работ по дезинфекции стен.
- Проводите удаление грибка летом, в теплую и сухую погоду. Обязательно дополнительно просушите обрабатываемую поверхность. Для этого можно воспользоваться тепловентилятором или феном.
- Снимите со стен обои или декоративное покрытие. Удалите с пораженных мест штукатурку. Постарайтесь убрать, как можно больше, ведь грибница плесени часто распространяется далеко за пределы видимого поражения. Используйте шпатель и жесткую щетку, чтобы тщательно очистить кирпичную кладку.
- Чтобы раскрыть поры кирпича, обработайте кладку составом для удаления следов штукатурки и цемента. Просушите стену еще раз.
- Нанесите на всю стену валиком бактерицидное средство. Используйте специальные антисептические растворы, в отличие от народных средств они могут бороться с различными видами грибков, плесени и патогенных бактерий. Привычные хозяйкам средства, такие как мочевина или купорос, убивают один вид грибка и создают благоприятную среду для других.
- Загрунтуйте стену с использованием акрилатного антисептического грунта. Это необходимо, чтобы обеспылить стену и повысить ее адгезию.
- Валиком или широкой кистью нанесите на всю поверхность стены гидроизоляционный раствор, чтобы предотвратить в дальнейшем проникновение сырости в слой штукатурки. После высыхания гидроизоляции еще раз обработайте стену антисептическим грунтом.
- Теперь стена готова к нанесению штукатурки. Когда штукатурка высохнет, обработайте ее специальной теплоизоляционной краской. После этого стену необходимо зашпаклевать и хорошо просушить.
- Только после финальной сушки на обработанные поверхности можно наносить декоративное покрытие: клеить обои, керамическую плитку или устанавливать стеновые панели.
Полезные советы
Если вы живете в частном доме, обязательно обработайте стену дома снаружи гидрофобными материалами. Подобную работу в городе обязаны проводить работники вашего домоуправления.
Часто причиной намокания стены является нарушение в работе дождевого слива с крыши. В этом случае стоит объединиться собственникам нескольких квартир и требовать устранения неполадки.
Видео: Как избавиться от плесени. Удаляем плесень в доме
Как избавится от плесени, грибка в квартире народными средствами
Люди борются с плесенью давно. Эффект различный. Иногда и положительный. Но если раньше людей волновала только эстетическая сторона проблемы: плесень некрасиво выглядит и ухудшает внешнее восприятие помещение, то сейчас ученые доказали безусловный вред и опасность плесени для здоровья человека. Самые различные болезни подстерегают человека, если он живет в помещении с плесенью и употребляет заплесневелые продукты. Рассмотрим, как можно избавиться от плесени, грибка или хотя бы уменьшить их количество вокруг нас, улучшить качество нашей жизни.
Виды плесени
Плесень представляет собой живые, разрастающиеся в виде ветвящегося мицелия грибы. Плесень иногда бывает и полезной.
- Aspergillus niger используют для производства сахаристых веществ и лимонной кислоты, а также витамина В2 (рибофлавина). Но в естественных условиях Aspergillus niger является самой опасной для здоровья человека и животных черной плесенью. Это именно то, что мы видим сырых углах помещений, под старым кафелем в ванной, в погребе, сарае, гараже и так далее. В фазе плодоношения этот грибок рассеивает споры, которые попадают в наши органы дыхания и отравляет наш организм. Иногда черная плесень вырастает и на хлебе.
- Botrytis cinerea в своей несовершенной стадии используется для производства вина, в частности хереса. Этот грибок даже называют благородной гнилью, так как он помогает создавать сырье с повышенной сахаристостью. В народе Botrytis cinerea получил название серой плесени. Он вырастает и на стенах помещений, особенно деревянных, но предпочитает селиться на живых растениях. Если у вас на приусадебном участке начала загнивать земляника или помидоры, то, скорее всего, их поразила серая плесень. Эта плесень не так опасна, как черная, однако дышать ее спорами тоже не стоит, а также употреблять в пищу продукты, пораженные Botrytis cinerea.
- Penicillium тоже считается благородной плесенью, используемой для производства сыра. Сыр бывает пронизан сине-зелеными спорами этого гриба или покрыт сверху коркой из этой плесени. Из Penicillium также делают антибиотик пенициллин. Им лечат воспалительные процессы. Но при ослаблении организма этот грибок тоже может поселиться в нем, вызывая различные болезни, в том числе со смертельным исходом. Penicillium в основном селится на продуктах, поэтому для длительного хранения их стерилизуют, кипятят и так далее. Иногда он появляется на деревянных поверхностях в доме, особенно если они влажные.
- Существует еще белая плесень. Ее тоже используют для производства сыров. Но она может поселиться и в квартире. Ее тоже нужно истреблять, хотя она и не так опасна для здоровья, как вышеперечисленные виды.
- Обычные дрожжи тоже являются плесенью. Хотя мы активно используем их в пищу, но многие ученые считают, что это тоже вредно для здоровья.
Плесень в квартире. Что делать?
Как мы уже говорили, наиболее опасной в квартире является черная плесень. Поэтому чаще всего на форумах люди спрашивают, как бороться с черной плесенью. Эта плесень очень опасна. Поэтому ее сначала аккуратно снимают со стен, защитив органы дыхания респиратором или марлевой повязкой, чтобы не надышаться спорами. Это называется механическим удалением. Затем поверхность нужно обработать, например медным купоросом, разбавленным формалином или смесью алюмокалиевых квасцов, железного купороса и поваренной соли. Химическая обработка может проводиться и при помощи зажженной серы. Продукты горения серы убивают все возможные грибки.
Плесень в доме из дерева можно убить креозотом. Но внутренние помещения, где живут люди, им не обрабатывают из-за сильного запаха. Если обнаружена плесень на стенах, а они деревянные, то их можно покрыть олифой. Но это не всегда удобно сделать, обнаружив плесень на полу или плесень на мебели. Тогда можно натереть на терке хозяйственное мыло, смешать с мочой, настаивать смесь сутки, а потом протереть дерево. Потом нужно промыть, а то будет продолжать пахнуть. Плесень в шкафу можно уничтожать так же. Людям издревле известны способы борьбы с плесенью на деревянных поверхностях, ведь дома изначально все были деревянные.
Если обнаружена плесень на стенах, а они не деревянные, можно использовать соль «Бишофит».
Иногда обнаруживается плесень на обоях. Как бороться, не всегда ясно. Ведь обои потеряют внешний вид, если их чем-то обработать. Лучше всего сделать ремонт и заменить обои, предварительно смочив стены биоцидом.
Если у вас появилась белая плесень, как бороться с ней тоже подскажет наша статья. Белая плесень часто появляется в цветочных горшках, а потом поражает всю квартиру. Хотя она не так опасна для здоровья, как черная плесень, избавляться от белой плесени тоже необходимо. Можно использовать те же средства, как и для борьбы с черной плесенью. Если плесень в подвале, где хранятся овощи, можно поставить там ящик негашеной извести. Хорошо помогает убить грибок.
Иногда в цветочных горшках или в аквариуме появляется зеленая плесень. Она тоже вредная. Как избавиться от зеленой плесени, люди тоже знают давно. Все вышеперечисленные методы можно применять. Однако следует помнить, что наибольшую надежность в борьбе с любыми видами плесени дают химические препараты. Их можно купить в специальном магазине. Если вы хотите получить быстрый и надежный результат, обратитесь к профессионалам. Особенно если плесень поразила большие участки вашего дома.
Хорошим методом профилактики плесени является проветривание помещения, просушивание вещей, в том числе и продуктов питания. Необходим быстрый ремонт испортившейся сантехники. Капающая вода приводит к развитию сырости. Плесень обычно хорошо размножается в темноте и непроветриваемых, теплых, влажных местах. В сухих и хорошо освещенных плесень живет редко. Поэтому такого рода профилактика от развития плесени сэкономит ваше время, деньги и нервы.
Видео: Плесень стен (mold on walls). Чем вывести навсегда.
еще способы как избавится от пятен ржавчены на потолке
sdelalremont.ru
Как убрать плесень со стен в домашних условиях
Грибок и плесень внезапно появившиеся у вас в доме, зачастую становятся возбудителем многих заболеваний. Важная задача обнаружить и нейтрализовать эту проблему на ранней стадии. Как же избавится от плесени на стенах народными способами, как нейтрализовать грибок в домашних условиях и пойдет разговор в этой статье.
Виды плесени у нас в доме
Плесень и грибок, который может появиться у нас в жилище может быть нескольких видов:
- Белая плесень – проявляется как реакция от чрезмерного полива цветов, так же от использования некоторых видов удобрений. Реакция человеческого организма может проявиться в виде аллергии;
- Зеленая плесень – поражает продукты питания, может спровоцировать серьезные заболевания. В редких случаях проявляет себя на стройматериалах;
- Черная плесень – самая опасная. Самый распространенный вид плесени, поражает все строительные материалы. Соседство с ней может обернуться вам бессонницей, головокружением, повышение температуры и головными болями. А в худших случаях: астма, бронхит, дерматит, пневмония и рак легких;
- Синеватая плесень – проблема всех деревянных поверхностей, разрушает слой краски и лакокрасочного покрытия;
- Плесень гниения – еще один вид плесени уничтожающий древесину;
Чем опасна плесень
Многие из нас обнаружив плесень откладывают на потом её удаление, когда появится время, появятся деньги и т.д. И это может обернуться чревато для их здоровья. С развитием плесени у вас дома также могут и развиваться многие болезни такие как:
- Астма и аллергия
- Приступы удушья и постоянно заложенный нос
- Экземы и дерматит
- Бронхит и другие заболевания дыхательных путей
Поэтому при обнаружении грибка у вас дома начинайте борьбу не откладывая, выйдет дороже.
Интересный факт: Особый и очень дорогой деликатес – колбаса с плесенью, которую делают в Италии. Колбаску выдерживают в подвальных помещениях около месяца, после чего она покрывается светло-зеленой плесенью и отправляется на специальную обработку, и уже через три месяца ей можно полакомиться.
План мероприятий по уничтожению плесени
От плесени нельзя избавиться сразу. Главная и основная причина появления грибка — это повышенная влажность, особенно это становится заметно осенью перед отопительным сезоном. Когда на улице становится холодно и сыро, а в квартирах еще не затопили. И причин повышенной влажности очень много:
- Полное отсутствие или не работающая вентиляция
- Плохая циркуляция воздуха в помещении
- Остаточная влажность (60 – 80%). В основном страдают ванная комната, душевая, санузел
- Старая гидроизоляция стен и межпанельных швов
- Неисправная сантехника (конденсат и течь)
Исходя из всего этого нужно обнаружить первопричину и удалить ее, иначе все наши труды пойдут насмарку.
Способы избавления
Существует несколько способов избавиться от плесени и грибка:
- Механический — утепление наружных стен или замазка швов, так же монтаж или чистка вентиляционной системы
- Удаление плесени паром — пароочистители используют довольно часто и на больших зараженных участках
- И третий способ — это применение препаратов, разработанных для борьбы с плесенью, которые в свою очередь можно разделить на домашние и покупные
Средства от плесени в домашних условиях
Все народные рецепты, основаны на веществах которые можно найти в каждом доме: уксус, хлорка, спирт (нашатырный или этиловый), марганцовка, бура, перекись водорода и ароматические масла. Так же стоит помнить, что и при работе с этими веществами стоит использовать средства защиты (респиратор и перчатки лишними не будут). И еще одно, вы должны понимать, что все домашние средства будут эффективными при небольших участках заражения или же на начальных стадиях. При запущенных случаях вам поможет только профессиональная химия, и это еще одна причина не затягивать с грибком.
Отбеливатель (хлорка) — уничтожает все виды плесени. Подходит для обработки: плитки, стёкол, стен. Раствор изготавливается в пропорции 1:10 с водой (на 1л готового раствора, берем 100 мл отбеливателя и 900 мл воды). Обработку производить кистью, валиком или распылителем, дать высохнуть.
Уксус — подойдет для обработки всех поверхностей, можно использовать как в чистом виде, так и на пару с содой. В чистом виде распылять на поражённые участки и дать высохнуть, через несколько дней процедуру повторить. Если используете на пару с содой, то изначально участок просыпаете содой, а потом поверх распыляете уксус. После химической реакции остатки счистить и промыть водой.
Перекись водорода — в основном применяется 3% раствор, методом распыления наносите на участок, через 15 — 20 минут очищаете. Рекомендуется для всех поверхностей, осторожно с окрашенными поверхностями и при обработке тканей.
Нашатырный спирт — токсичен, но обладает очень хорошими фунгицидными (уничтожение грибков) свойствами. Рабочий раствор в пропорциях 1:1 с водой, обработка распылением или кистью. Через час смыть водой, не смешивать с отбеливателями (выделение токсичного газа).
Бура — продукт натурального происхождения, естественный ингибитор (предотвращает или задерживает развитие). Разводится в соотношении 1:10 с водой и наносится методом втирания щеткой, дальнейшая отделка после полного высыхания.
Медный купорос — используется давно и довольно успешно. Смешивается 100 гр купороса на 10 литров воды, обработку производим любым методом. Единственный минус после использования может появиться голубоватый оттенок.
Мыльный раствор — смесь хозяйственного мыла и воды в основном применяют как профилактическое средство.
Эфирные масла — применяются, как и мыльный раствор в основном для профилактики. Масла чайного дерева, лаванды и розмарина имеют антибактериальное свойство и приятный запах. Разводим в соотношении 10 капель на стакан воды, обрабатываем и даем высохнуть.
И еще один способ поможет вам избавиться от плесени в ванной (плитка и швы), берем в равных количествах стиральный порошок, уксус и воду (100 гр, 100 мл). Обработайте на 10 минут и после протрите щеткой.
Живу бедно: сыр ем с плесенью, вино пью старое, машина без крыши, телефон без кнопок.
Как бороться с запахом плесени
Если плесень вы уже победили, но запах еще остался вот вам несколько советов:
- Возьмите пищевую соду и насыпьте на место обработки на несколько часов, после уберите пылесосом
- Древесный уголь – расставьте в комнате емкости с углем и оставьте на несколько дней
- Хорошее проветривание и после обработайте комнату благовониями, арома свечами, аэрозолями
Профилактика от плесени и грибка
- Контролируйте влажность в помещениях — используйте вытяжку при готовке, проветривайте комнату и оставляйте открытые двери в ванную комнату. Пользуйтесь кондиционером для осушения воздуха
- Поддерживайте постоянную температуру в комнатах — утеплите окна, используйте отопление или обогреватели
- Цветы в горшках — герань и фиалки, не переливайте воду
Выводы от Тихона: Избавиться от грибка можно, главное в этом деле не «запустить» распространения. Проводите профилактику, проветривайте помещения, поддерживайте температурный режим.
Если вы имеете опыт с обработкой плесени, поделитесь им в комментариях ниже. Возможно ваш совет поможет кому-то принять правильное решение.
Счастье вам и вашему дому.
klopovich.ru
Как эффективно избавиться от черной плесени на стенах квартиры, видео

Немаловажно знать, как избавиться от черной плесени на стенах, так как такой вид грибкового произрастания может привести как минимум к тяжелым респираторным заболеваниям. Любая разновидность плесени в доме очень вредна и опасна для здоровья человека. Она может появиться как на продуктах питания, так и на разнообразных поверхностях в помещении. Микроскопические грибные скопления от светло-зеленого до черно-бурого цвета на стенах являются признаками нарушения эксплуатации помещения, его неправильного проветривания и, собственно, самой технологии строительства.
Сущность проблемы
Если ее своевременно не ликвидировать, то впоследствии плесень способна разрушить тот строительный материал, на котором произрастает, а также вызвать его коррозию и ухудшить внешний вид помещения.
В действительности, микроскопические грибковые споры, в народе именуемые как плесень, обитают практически везде и переносятся ветром вместе с частичками пыли по воздуху. Наиболее комфортабельной средой для их обитания и размножения является сырость в помещении, плохое вентилирование помещения, а также низкая температура воздуха в нем.

Профилактика и перечень мероприятий по удалению плесени на стенах
Помимо разрушающего эффекта строительного материала, неэстетичного вида помещения, споры черной плесени, а вернее грибок аспергилл, попадая в организм человека, может вызвать аллергическую реакцию, приступ удушья или головную боль. Такие вредоносные образования на стенах могут поразить ЦНС, кожу, пищеварительную, дыхательную и даже половую систему, а это, в свою очередь, в совокупности с другими предрасполагающими факторами, например, на фоне иммунодефицита, может привести к смерти. В связи с этим, чтобы не допустить появление «невидимого врага», то есть предотвратить его появление или избавиться от черной плесени на стенах в доме навсегда, рекомендуется выполнять следующий перечень профилактических мероприятий:
- Систематически и постоянно проветривать все помещения в доме, особенно туалет и ванную комнату.
- Как можно чаще проводить уборку помещений.
- При расстановке крупногабаритной мебели в комнатах не ставить мебель плотно к стенам, чтобы избежать впоследствии конденсата на обеих поверхностях − самой благоприятной среде для обитания грибка.
- Не допускать повышения влажности в помещениях дома.

При невыполнении мер по профилактике плесени на поверхностях (стенах, потолке, углах и т.д.) бороться с плесенью можно следующими средствами:
- Формалин. Весьма ядовит, поэтому категорически запрещается допускать его попадание как на кожные покровы, так и на пищевые продукты. Его необходимо просто в небольшом количестве развести в воде и при помощи марлевого или ватного тампона смочить, а затем аккуратно удалить плесень с поверхности стен, потолка и т.д.
- Медный купорос. Менее опасный компонент, добавляемый в обычную воду, которой затем рекомендуется в течение 1-2 месяцев обрабатывать пораженные плесенью участки при помощи марлевой или кухонной тряпки.
- Антраценовое масло, а также эфирное масло монарды (известной, как бергамот дикий или мелисса), лаванды и чайного дерева. Эти редкие, но не менее эффективные средства также будут полезны в борьбе с плесенью, причем действие их достаточно продолжительно.
- Хлоросодержащие вещества, например, отбеливатель, которые можно приобрести в магазине и протереть ими пораженную поверхность.

Как уничтожить вредоносные образования?
Не секрет, что избавиться от черной плесени на стенах обыкновенным физическим способом можно лишь на непродолжительное время. В связи с этим, желательно в период отделки помещения выполнить несколько несложных антигрибковых обработок поверхности стен помещений. Для этого потребуется приобрести в магазинах строительного профиля специальные дезинфицирующие средства и при отделке стен добавить их в небольшом объеме в раствор.
Традиционными народными средствами по борьбе с плесенью считаются хлорсодержащие дезинфицирующие вещества, такие как: отбеливатель, в составе которого содержится хлор, а также высококонцентрированный раствор на основе хоз. мыла. Можно с этой же целью использовать 50 г медного купороса на 5 л воды.
В случае появления плесени уничтожение нужно будет начать с очистки зараженного места, а при более глубоком проникновении грибка в слои отделки потребуется отскоблить все пласты отделочных материалов вплоть до бетонной или кирпичной поверхности.
Таким образом, удаление плесени с поверхности стен помещений состоит из следующих этапов:
- Тщательной просушки зачищенного от плесени участка стены, которую можно осуществить при помощи газовой или бензиновой горелки, бытового вентилятора.
- Обработки всего участка антигрибковым веществом при помощи распылителя, кисти, либо валика.
- Грунтованием и нанесением гидроизолирующей смеси.
- Оштукатуриванием стены по-новому и шпаклевкой ее под финишную отделку.
Важно! Все работы, по удалению плесени рекомендуется в индивидуальных защитных средствах — резиновых перчатках, респираторной маске и плотной полностью покрываемой кожный покров одежде.
Рекомендации по избавлению от неприятного «амбре»
Решая, как избавиться от черной плесени на стенах, необходимо также иметь в виду, что она по мере разрастания выделяет специфичный запах. Поэтому, чтобы очиститься от него, помещение после ликвидации источника (плесени) несколько раз дезодорируют, к примеру, хлорным отбеливателем или содой, а затем хорошенько проветривают.

Черная плесень чрезвычайно разрушительна и имеет весьма отвратительный запах. В связи с этим, устраняя грибок плесени на различных поверхностях – кафельной плитке, гипсокартоне, деревянном покрытии или обоях, следует тщательно проследить за тем, чтобы её источник был ликвидирован.
Хорошим средством по избавлению не только самой плесени, но и от запаха, является раствор, состоящий из 1 части борной кислоты, 2 частей перекиси водорода, а также 2 частей белого уксуса и 4 частей воды.
Важно! После ликвидации плесени участок поверхности, на котором находилась плесень, необходимо хорошенько просушить феном либо любым другим источником теплого воздуха.
Чтобы убрать запах плесени из комнат, также можно посыпать обработанный проблемный участок питьевой содой, оставить её для воздействия (поглощения) на 2 часа, а затем собрать пылесосом. Сода поглотит не только запах плесени, но и избыток влаги.

Помимо вышеописанных способов по удалению плесени и её запаха, с целью недопущения повторного появления вредоносного для строительных материалов и опасного для здоровья человека грибка, рекомендуется соблюдать и выполнять следующие мероприятия:
- Не допускать переохлаждение каркасных стенок в помещениях.
- Своевременно осуществлять ремонт смесителей и водопроводов.
- В период восстановительных и ремонтных работ использовать устойчивые к влаге материалы.
- Не сушить в закрытом помещении влажное белье.
- Постоянно проветривать помещение и установить в комнатах с повышенной влажностью воздуха осушитель либо кондиционер с контролем уровня влаги в помещении.
Совет! Уделяйте как можно больше внимания и времени своему дому, тогда никакой недуг не проникнет в него.

Просто выполняйте даже в небольшом объеме мероприятия по защите жилого строения, и избавиться от черной плесени на стенах в случае её возникновения будет намного легче.
koffkindom.ru
3 способа как избавиться от черной плесени
Черная плесень это такой грибок, который часто появляется в темных влажных местах. Каждая домохозяйка знает, что это такое. Это головная боль, которая распространяется с огромной скоростью. Мало кто понимает, что это такое. И все задаются вопросом, как избавиться от черной плесени. Хорошо, что избавиться от нее можно многими способами и все, что для этого надо, есть в хозяйстве в любой квартире. Напомним, что в генеральную уборку, обязательно входит удаление черной плесени.
Способ 1 – Чистящие средства
-
Знаете, что такое бура? Это натриевая соль борной кислоты. Если вы не разбираетесь в химии, не пугайтесь. Купить ее можно в любом хозяйственном магазине. Применять ее можно и на плитке и на стекле и на пористых поверхностях (цемент, дерево). Прежде чем приступить к удалению грибка, вам нужно пропылесосить участок заражения. Но делать это лучше всего пылесосом с HEPAфильтром, так как обычным пылесосом вы разнесете споры по всей квартире. Далее вам нужно смешать на 4 литра воды 1 стакан буры. Возьмите щетку с жестким ворсом. Мокните ее в раствор с бурой и начинайте тереть зараженное место. Затем сухой тряпкой протрите это место, но не смывайте водой, если не хотите чтобы плесень опять появилась.
-
При помощи моющих средств, можно очистить плесень. Удалить полностью не получится, но отчистить сможете. Применять его можно, только на гладких поверхностях, таких как стекло и кафель. На 4 литра воды смешайте 1 стакан стирального порошка. Жесткой щеткой нанесите его на поверхности и начните тереть плесень. Сполосните чистой водой область.
-
Одно из самых эффективных средств и в то же время самое опасное – это использовать аммиак. Нужно взять совсем небольшое количество аммиака, для того чтобы уничтожить даже самое запущенное заплесневелое место. При чем, на чем она не имеет значения. Это может быть и дерево, и плитка, и цемент, и стекло. Налейте в пульверизатор 2 стакана воды и стакана аммиака. Распылите получившийся раствор на пораженную поверхность и оставьте на 2 часа. Протрите поверхность чистой водой и прострите.
-
Отбеливателем можно убить все живое. В том числе и плесень. Это самое эффективное средство. Но применить его можно только на гладких поверхностях. Будьте осторожны с цветной отделкой. Вместе с плесенью могут исчезнуть и краски. Обеспечьте хорошую вентиляцию в помещении. И ни в коем случае не комбинируйте аммиак и отбеливатель, а то вместе с плесенью вы и себя отравите. После того как вы оденете резиновые перчатки смешайте на 4 литра воды 1 стакан отбеливателя. Залейте раствор в пульверизатор или нанесите его на пораженное место с помощью губки. Оставьте раствор на час.
Способ 2 – зеленые средства
Способ 3 – удаление черной плесени в массовых количествах
-
Если поверхность деформировалась или от нее сильно пахнет сыростью, то скорее всего там будет плесень. Это может быть под ванной или раковиной. Между гипсокартонными стенами или в дверных проемах. Так же плесень часто появляется на потолке, так как теплый воздух поднимается к верху.
-
Если масштабы пораженной поверхности большие, а потери огромные, то проще полностью заменить элемент. К таким проблемным местам может относиться плитка, ковролин, половицы, подвесной потолок.
-
Прежде чем приступать к замене или чистки, заклейте все отверстия и щели полиэтиленом. Это необходимо чтобы споры не попали в другие помещения. Оставьте только вентиляционные отверстия, которые не ведут в помещения.
-
Обязательно оденьте защиту. Очки, респиратор, комбинезон (или просто старую одежду, которую не жалко выкинуть), перчатки.
-
Все что вы удалите обязательно упаковывайте и заклеивайте скотчем. Заверните пораженные элементы отделки в мусорные мешки. Ни в коем случае нельзя допустить распространение спор черной плесени.
-
Если площадь огромная, то вам потребуется помощь профессиональной службы.
-
Все из-за влажности, поэтому помимо удаления плесени вам еще нужно исправить микроклимат в помещении. Возможно это плохая вентиляция или протекающие трубы. Может плесень идет из подвала или с чердака. Вам нужно все обследовать и исправить.
Советы
Обращайтесь в нашу клининговую компанию.
Черная плесень опасна, особенно для людей с аллергией или респираторными заболеваниями. А так она является возбудителем таких заболеваний. Следите за своим здоровьем и как только обнаружите плесень, немедленно и безжалостно уничтожайте ее.
Предосторожности
Для кошек и собак масло чайного дерева смертельно опасно. Держите его подальше от своих питомцев.
Упаковывая зараженные участки, обязательно качественно заворачивайте их в пакеты. Можно один пакет в другой и для надежности заклеить его еще скотчем.
Сложнее всего приходится с пористыми покрытиями. Проще заменить затирку в ванной, чем стараться оттереть и придать ей первоначальный вид.
А что вы думаете по этому поводу? Что еще можно добавить к вышесказанному?
cleanqueen.ru
эффективные способы уничтожения и выведения / Как избавится от насекомых в квартире

Борьба с плесенью в квартире
Плесень не только портит внешний вид помещения, но ещё и опасна для здоровья. Именно поэтому борьба с плесенью должна быть эффективной и своевременной.
Немного о плесени
Плесень — грибок, который развивается в подходящих условиях
Для начала следует выяснить, что такое плесень. Это грибок, который может легко распространяться по воздуху. Микроскопические споры разлетаются, оседают на различных поверхностях и при благоприятных условиях начинают размножаться. Удивительно, но грибки всеядны и очень живучи. Они могут обитать на любых поверхностях: на дереве, пластике, кирпиче и даже бетоне. Споры плесени были обнаружены под ядерным реактором в Чернобыле, а также на космической станции «Мир». Споры плесени в помещении находятся не только на поверхностях, они есть и в воздухе, поэтому могут попадать в организм человека. Существует множество видов грибков. Наиболее распространены грибки гниения, синевы, а также плесневые.
Плесень начинает развиваться только при благоприятных условиях, к которым относятся: плохая вентиляция, постоянная температура, а также повышенная влажность. Распознать наличие грибка можно по скоплениям спор. Они выглядят как мелкие или довольно крупные пятна синего, чёрного, жёлтого, серого или других цветов. Кроме того, плесень может иметь характерный запах, который будет особенно заметным, если скопления грибков значительные и многочисленные.
Как подготовить помещение к борьбе?
Как правило, грибки обитают в нескольких местах помещения. Кроме того, они проникают в поры материалов, так что если вы просто произведёте генеральную уборку, то не избавитесь от проблемы. И поэтому прежде чем начинать уничтожение плесени, помещение нужно подготовить. Основные этапы подготовки:
- Будьте готовы к тому, что вам придётся делать ремонт, причём не косметический, а полноценный и капитальный. Со стен и пола придётся удалить все отделочные материалы. Если действовать локально, то оставшиеся в не имеющих видимых следов поражения местах споры продолжат размножаться, и проблема возникнет вновь.
- Уберите всю одежду, постельное бельё и прочие предметы. Бельё и одежду выстирайте в горячей воде с добавлением специальных средств, предметы тщательно очистите.
- Грибки обитают и в мебели (большинство видов размножается на деревянных поверхностях), так что разложите мебель. Обработать нужно будет все части, уделяя особое внимание труднодоступным местам.
- Со стен и полов уберите все ковры, а также картины и другие предметы. Они тоже будут подвергаться обработке.

Подготовка — важный этап в борьбе с грибком
Как бороться?
Уничтожение плесени должно быть комплексным и целенаправленным, то есть предполагающим устранение причин её возникновения. Перечислим основные способы.
Меняем условия
Чтобы уничтожить плесень, нужно сначала создать в помещении условия, в которых грибки не будут размножаться. Для этого проведите следующие мероприятия:
- Обеспечьте доступ кислорода в помещение. Если плесень находится в одной из жилых комнат или на кухне, то постоянно производите проветривание. В первое время окна должны быть открытыми практически постоянно. Затем нужно будет проводить процедуру минимум дважды или трижды в день по 15-30 минут. Если же грибки обитают в ванной комнате или в туалете, то оцените исправность вентиляции. Она непременно должна обеспечивать доступ свежего воздуха. И старайтесь как можно реже закрывать двери в помещение.
- Уберите со стен и полов ковры. Большинство из них (особенно изготовленные из синтетических материалов) создают идеальные условия для размножения плесени. Например, если вы вымыли пол и сразу же застелили его ковром, то влага успеет испариться, а кислород перестанет поступать. И это идеальные условия для размножения грибков.
- Не сушите бельё на батареях. В этом случае испаряющаяся влага будет создавать идеальные условия для размножения плесени. Лучше всего сушить вещи на специальных сушилках, а в тёплое время года на балконе.
- Ни в коем случае не складывайте в шкафы не высохшие до конца вещи. В закрытом пространстве они повысят влажность, что приведёт к размножению грибков.
Процесс обработки помещения
- Следите за влажностью. Она может повышаться по разным причинам, так что устраните все возможные. Во-первых, заделайте все щели, имеющиеся в стенах или в полу, влага вполне может проникать через них. Во-вторых, проверьте всю сантехнику, имеющуюся в доме: краны, раковины, унитаз. Устраните все течи и щели, чтобы влага не оставалась на поверхностях.
- Поставьте качественные окна. Они не должны пропускать влагу извне, а также создавать конденсат. Обеспечьте полную герметичность.
- Старайтесь реже закрывать двери, ведущие в комнаты, чтобы обеспечить оптимальную циркуляцию воздуха.
- Обеспечьте хорошую гидроизоляцию квартиры или дома, используя специальные материалы.
Использование специальных средств
Как вывести плесень с помощью специальных средств? Сегодня в продаже можно найти немало специальных препаратов – антисептиков. Они оказывают фунгицидное (противогрибковое), а также антибактериальное воздействия, что позволяет разрушить и полностью удалить споры.
Все антисептики можно условно разделить на три группы:
-
Противогрибковый антисептик
Водорастворимые. Они растворяются в воде, так что считаются самыми безопасными и малотоксичными. Запах большинства таких средств нерезкий, выветривается он быстро. - Препараты, растворимые скипидаром. Скипидар имеет явный запах, так что использование средств данной группы может доставлять дискомфорт жильцам.
- Средства, растворимые уайт-спиритом, считаются самыми токсичными и вредными.
Что касается формы выпуска, то практически все средства выпускаются в виде жидкостей. Но существуют средства, которые добавляются в отделочные материалы (лаки, краски, шпаклёвки или грунтовки), что весьма удобно. Кроме того, выпускаются и специальные антисептические грунтовки, которыми покрывают стены непосредственно перед отделкой.
Чтобы борьба с плесенью была не только эффективной, но и безопасной, следуйте указаниям, данным в инструкции, приложенной к препарату. Кроме того, проводить обработку следует с использованием средств личной защиты: респиратора, защитных очков, перчаток и костюма.
Наиболее популярны и эффективны такие средства как «Тамак», «Атигрибок», «Биостоп», «Сенеж Антиплесень», «Тефлекс Антиплесень», «Реногал», «Пума», «Пинотекс», «Гидротекс», «Кроун», «Тиккурила» и другие.
Народные средства
Как бороться с плесенью с помощью народных средств? Предлагаем несколько проверенных рецептов:
Один из самых простых антисептиков — перекись водорода
Отбеливатели. Можно использовать обычный отбеливатель для белья. Чаще всего в состав таких средств входят антисептические компоненты.- Перекись водорода – популярный и известный антисептик, который уничтожит споры грибков.
- Уксус. Кислота прекрасно справляется с большинством распространённых видов плесени.
- Уничтожить плесень поможет нашатырный спирт. Но его лучше используйте для обработки непористых твёрдых поверхностей, так как в поры он не проникнет.
- Пищевая сода часто используется для удаления загрязнений и для дезинфекции. Как вывести плесень с помощью такого простого средства? Нужно просто растворить столовую ложку соды в половине стакана тёплой воды и обработать полученным составом поражённую поверхность.
НАШИ ЧИТАТЕЛИ РЕКОМЕНДУЮТ!
Для избавления от насекомых наши читатели советуют отпугиватель Pest-Reject. Работа прибора основана на технологии электро-магнитных импульсов и ультразвуковых волн! Абсолютно безопасное, экологическое средство для человека и домашних животных. Подробнее здесь…Как проводить обработку: правила и особенности
Как бороться с плесенью в помещении? Борьба включает несколько этапов:
- Удалите отелочные материалы.
- Удалите споры плесени. Если поражение незначительное, то просто снимите скопление грибков тряпкой или губкой. Если же споры проникли в поры материала, то с помощью шпателя удалите шпаклёвку или даже часть бетона или кирпича (для этого можно использовать перфоратор).
- Просушите поверхность с помощью обычного или строительного фена.
- Следуя инструкции, подготовьте средство, выбранное для обработки. Нанесите его на поражённые участки, а лучше обработайте всю поверхность.
- Спустя 4-6 часов вновь просушите поверхность и очистите её, затем снова нанесите антисептик.
- Примерно через 12 часов снова проведите тщательную сушку и приступайте к отделочным работам. Чтобы избавиться от грибка наверняка, используйте антисептическую грунтовку или добавьте антисептическое средство в шпаклёвку или краску.
- После обработки не забывайте соблюдать правила профилактики. Следите за влажностью и чаще проветривайте комнату.
Пусть борьба с грибками будет эффективной.
eparazit.ru
Уничтожение плесени
Очень многие не задумываются о таком вопросе, как уничтожение плесени у себя в квартире, в частности — в ванной комнате. Если присмотреться к стенам давно не ремонтированной ванной комнаты, можно часто заметить там небольшой или уже обширный грибок. Этот краткий обзор поможет вам понять, как уничтожить плесень в ванной, если таковая поселилась основательно.
к содержанию ↑Как выглядит грибок?
Плесень может выглядеть по-разному, это зависит от поверхности, которая ею поражена:
- В ванной на плитке она обычно белого, желтоватого цветов.
- Если повреждено дерево и обои, то грибок имеет оттенки серого и черного.
Чем вредна плесень?
- Разрушает покрытия и их структуру. Если вы вовремя не приметесь за уничтожение плесени и грибка, то небольшой косметический ремонт перерастет в капитальный.
- Вызывает заболевания дыхательных путей и слизистых оболочек. Отнеситесь к этому пункту серьезно, потому что плесень зачастую способствует заболеванию туберкулезом. Именно поэтому заключенные в советских тюрьмах болели именно им — там было очень много плесени.
- Распространяет неприятный затхлый запах.
Как и почему грибок возникает в доме?
Причин для образования этой гадости несколько, но главной остается одна — повышенная влажность, много воды, конденсата.
Проблема старых домов
Давно не ремонтированные ванные комнаты, или же те, где ремонт был еще при Сталине, имеют плесень. Все без исключения, как там ни убирай. Старые трубы копят конденсат, сантехника протекает и от этого постоянная влажность, из сливного бачка постоянно течет струйка воды. Все это — идеальные условия для жизни и процветания грибка на ваших стенах.
Проблема новых домов
Но, как ни странно, в только что отремонтированных квартирах тоже может возникнуть плесень. Причина появления иная, но опять же — вызывающая влажность. Это металлопластиковые окна. Они вообще не пропускают воздух в дом и та вода, что есть в квартире, включая наше дыхание, никуда не уходит. Прибавьте к этому тепло и готово — грибок начал обретать четкие формы, а вы озадачились поиском средства, чтобы уничтожить плесень.
К слову о новом ремонте. Грибок может появиться и тогда, когда ремонт выполнен некачественно:
- поставили материалы, которые копят влагу;
- сделали неправильную гидроизоляцию швов.
А если вы еще и поклонник рыбок или комнатных растений и в вашем доме все это есть, грибок к вам придет обязательно. И тогда то, что вы считали нереальным, будет для вас самым актуальным, а именно — мысль, чем уничтожить плесень.
к содержанию ↑Важно! Все эти факторы работают в пользу плесени в основном тогда, когда помещение не проветривается. Плесень не любит сухого и свежего воздуха, ее стихия — застой.
Как предотвратить появление грибка?
Как и при любой другой проблеме, лучше бы ее избежать, заблаговременно подумав о мерах профилактики. Что вы можете сделать, чтобы не надо было уничтожать плесень? — Действия просты:
- Установить вентиляцию в ванной комнате.
- Заменить некачественную сантехнику.
- Проветривать свою квартиру регулярно.
- Не держать в ванной долго замоченные вещи.
- После купания проветривать ванную.
- Делать влажную уборку в квартире быстро.
- Зимой ставить обогреватели, которые способствуют сушке воздуха.
- Сделать правильную герметизацию окон, чтобы зимой не запотевали стекла.
Чем уничтожить плесень?
Прежде всего хочется сказать для тех, кто не хочет возиться и тратить на это свое ценное время, и кому проще доверить это дело профессионалам. Достаточно найти хорошую службу по вопросам быта, позвонить и заказать бригаду на дом. К вам приедут специально обученные люди, которые быстро справятся с этой проблемой.
Чем уничтожить плесень своими силами?
Убираем плесень в деревянном доме
Для очистки деревянных поверхностей используйте строительные антисептики для деревянных поверхностей. Но не стоит их применять в чистом виде. Разведите скипидаром или уайт-спиритом, полученный раствор нанесите на предварительно высушенную поверхность и через время повторите процедуру.
Для удаления грибка со стен придется снимать обои:
- Уменьшите в помещении влажность.
- Снимите обои.
- Просушите штукатурку и удалите рыхлую щеткой по металлу.
- Обработайте стену антисептиком.
- Нанесите грунтовку и штукатурку.
- Высушите и затем снова нанесите грунтовку.
- Высушите и заклейте стену обоями.
Уничтожение плесени и грибка в ванной комнате
Сначала необходимо просушить ванную, затем определить слабые места — то, что протекает или копит влагу. После того, как вы их найдете — замените их на новые. Не жалейте денег, пусть вы потратите сейчас то, что не планировали, зато потом у вас будет ароматная, сухая и красивая ванная комната.
Важно! Обязательно установите вентиляцию или проверьте уже существующую — возможно, вам удастся ее отремонтировать или просто будет достаточно прочистить вентиляционные каналы.
Теперь самое противное, но необходимое:
- Пораженные стены нужно полностью демонтировать: снять плитку, штукатурку, удалить краску.
- Желательно, чтобы во время ремонта, в ванной находился вентилятор или тепловой нагреватель.
- После того, как вы содрали все покрытия с пораженных участков, их нужно хорошенько просушить, обработать чистым антисептиком, оставить на время и затем покрыть все снова плиткой или тем, чем вы хотите.
Видеоматериал
Пусть то, что вы прочитали здесь, поможет вам содержать вашу квартиру сухой и комфортной, а мысль — как уничтожить плесень, у вас больше никогда не возникнет.
Поделиться в соц. сетях:
serviceyard.net